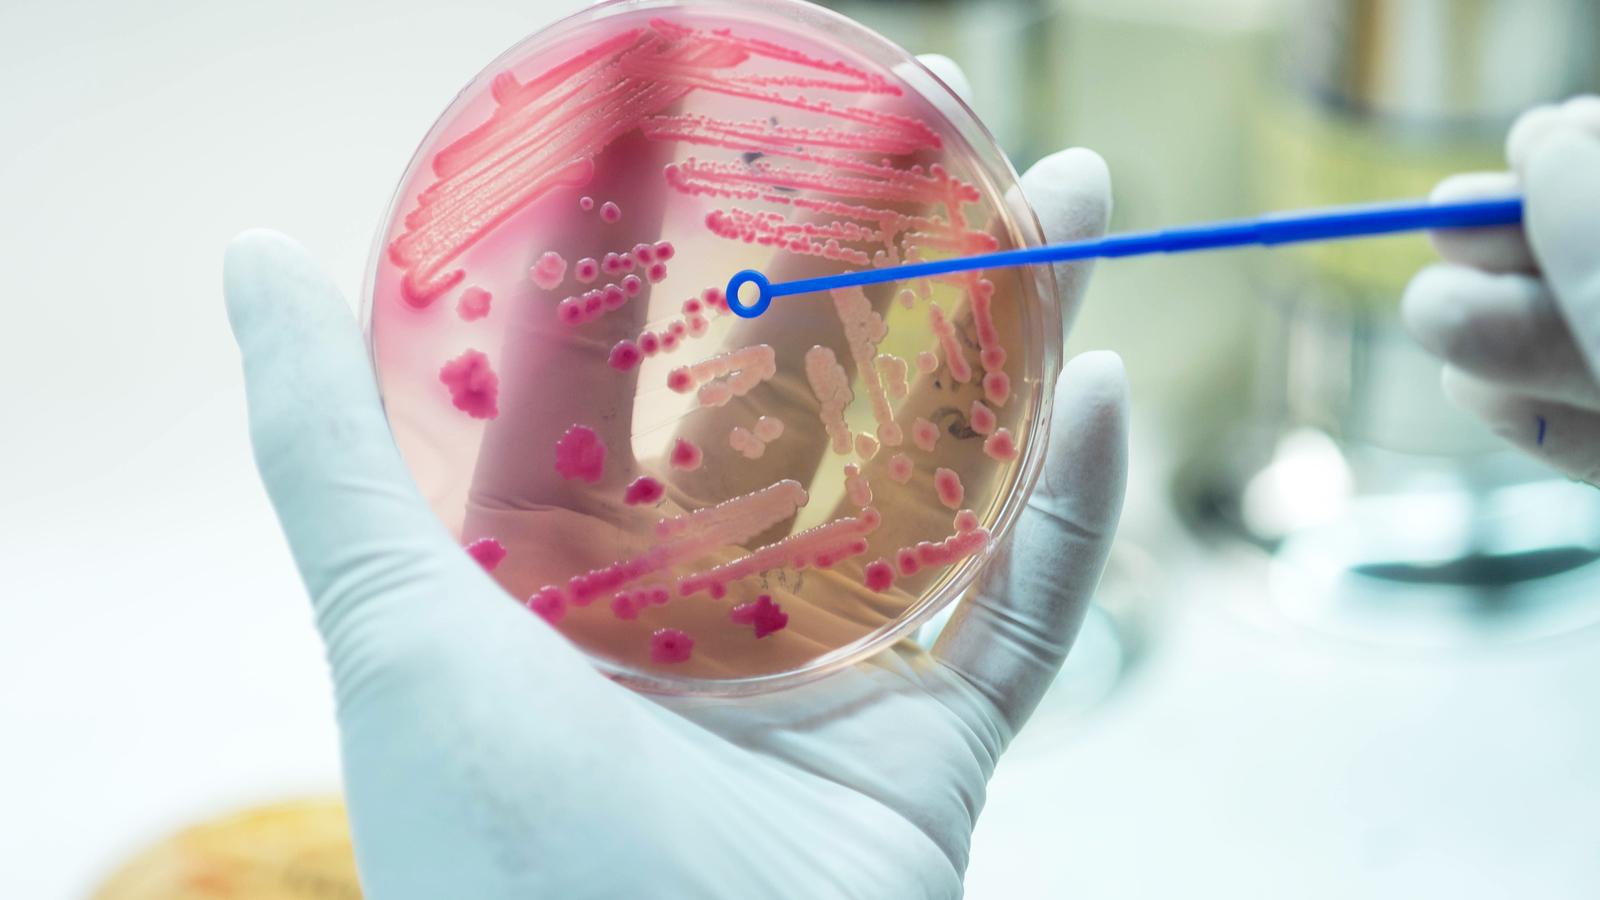

Új antibiotikumot fedeztek fel a szuperbaktériumok ellen
A Rockefeller Egyetem kutatói új antibiotikumot fedeztek fel talajmintákban, ami alkalmas lehet a nehezen kezelhető baktériumfertőzések kezelésére. Most a szer hatékonyságának növelésén dolgoznak, hogy mindenki számára elérhető orvosságot lehessen belőle kifejleszteni.
A tudósok több mint 1000 talajmintában kutattak olyan vegyületeket termelő mikroorganizmusok után, amelyek a kórokozók elleni harcban is hasznosíthatók. Ezeket genetikai szekvenálással, azaz az élőlény teljes örökítő anyagának feltérképezésével vizsgálták meg.
A Nature Microbiology szaklapban közzétett tanulmányból kiderül, hogy az új antibiotikum felveheti a harcot a nehezen kezelhető baktériumfertőzésekkel, többek között az MRSA (methicillinrezisztens Staphylococcus aureus) "szuperbaktériummal"szemben. A szert MRSA-fertőzött patkányokon tesztelték, a bőrükön lévő sebeket elmulasztotta a szer. „Bár a kutatási eredmények bíztatóak, egy újonnan felfedezett antibiotikum-családról lehetetlen megmondani, mikor jöhetnek a klinikai tesztek, de azt sem, hogy eljut-e ebbe a fázisba” - fel a figyelmet Sean Brady, a kutatás vezetője. Pedig hatalmas szükség lenne egy olyan hatóanyagra, ami képes legyőzni a gyógyszereknek ellenálló fertőzéseket, amiket a szuperbaktériumok okoznak, melyek a világ egyik legnagyobb egészségügyi fenyegetésének számítanak, megközelítőleg 700 ezer ember halálát okozzák évente.

Colin Garner, a brit Antibiotikumkutató Intézet munkatársa szerint üdvözítő a hír, hogy új antibiotikumot fedeztek fel az úgynevezett Gram-pozitív baktériumok ellen, mint az MRSA, ám a Gram-negatív baktériumok elleni szerre még nagyobb szükség lenne. „Az utóbbiakat nehéz megfékezni, egyre nő közöttük az antibiotikumoknak ellenállók száma. Ezek a baktériumok tüdőgyulladást, vérmérgezést, húgyúti és bőrfertőzést fertőzést okoznak” – mondta el Garner a BBC-nek.
Forrás:
http://www.bbc.com/news/health-43032602




